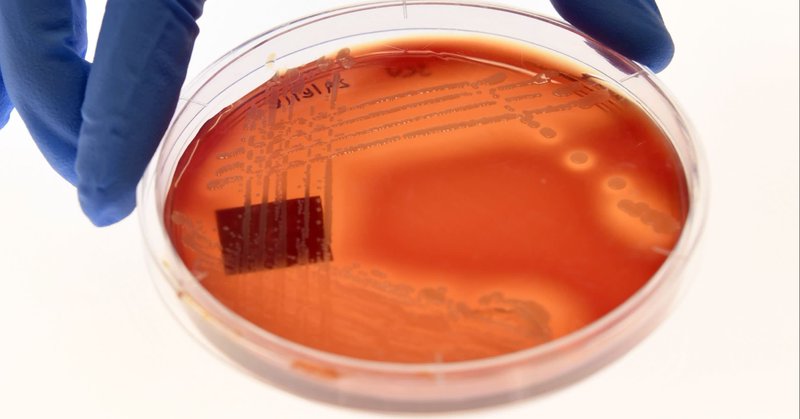

Clive Cookson
@clivecookson
Followers
6K
Following
867
Media
217
Statuses
2K
Senior science writer, Financial Times. All views are mine or borrowed from other people — and not necessarily the FT's.
London
Joined February 2009
The most recent AMR surveillance charts the continued rise of antibiotic-resistant superbugs https://t.co/RCG4TSnVSC via @ft
ft.com
Levels of antimicrobial resistance highest in south-east Asia and eastern Mediterranean
0
0
0
The latest in our series about longevity companies. A sisterly enterprise seeking to stop unwanted cell death. @LinkGevity
https://t.co/GZEZi2u8yf via @ft
ft.com
Cambridge-based LinkGevity focuses on preventing the process of necrosis
0
3
2
Scientists detail Delphi-2M, an AI model trained on large-scale health records that can predict susceptibility to over 1,000 diseases decades into the future (@clivecookson / Financial Times) https://t.co/00Og7oskan
https://t.co/gpGQoVQ90G
techmeme.com
Clive Cookson / Financial Times: Scientists detail Delphi-2M, a generative AI model trained on large-scale health records that can predict susceptibility to 1,000+ diseases decades from now
1
3
10
Gut guru Tim Spector moves on from popularising the human microbiome -- trillions of beneficial bacteria in our intestines -- to urge us to add a further multitude of microbes by making and eating as much fermented food as we can @timspector
https://t.co/j85sh2daDe via @ft
ft.com
The gut guru champions the benefits of consuming lots of kefir, kombucha, kimchi and kraut
0
0
1
Important new real-world evidence that AI may harm performance. @clivecookson @FT
https://t.co/o2QREpNbA2 Routine AI assistance hits skills of health experts performing colonoscopies
1
1
0
MODERATOR: Are you willing to commit to NOT raise the sales tax? MIKIE SHERRILL: I'm not going to commit to anything right now. On Nov. 4, vote NO on Mikie Sherrill. ❌
38
102
269
Experts warn the materials were causing extensive disease ‘at every stage’ of human life, ahead of UN talks on a global plastics treaty https://t.co/wcvr22EITz
17
75
135
A million thanks ABSW. Too emotional to say much more now than ‘what an honour’
🏆#ABSWawards 2025 🎉Lifetime Achievement Award🎉 Clive Cookson, Financial Times @clivecookson @FT 👏👏👏Congratulations!!! Clive Cookson became FT senior science writer in October 2023, after more than 30 years as science editor.
1
2
6
Organ ageing research shows that the brain is 'the guardian of longevity' https://t.co/Jc2ZoMjmFL via @ft
ft.com
Researchers develop blood tests to study ‘biological age’ of the body’s organs and tissues
0
0
2
Spritz Vibe. Limited Edition. Frosted over & fresh for the season, Spritz Vibe Sparkling Snowball Frost Limited Edition is here! CELSIUS. LIVE. FIT. GO.
453
732
10K
Two of our finest mathematical writers, Marcus du Sautoy and David Darling, have new books out about the intertwining of maths, music and artistic creativity. https://t.co/LADQEZcncF via @ft
ft.com
From Mozart and Dostoyevsky to Jackson Pollock — two books reveal the fundamental and sometimes surprising intertwining of mathematics and creativity
0
0
1
Some vaccines may offer double protection against dementia. New study suggests that they not only suppress viral infection but also modulate the brain's immune response through their added adjuvants https://t.co/HAB0wAVMbC via @ft
ft.com
Oxford research shows adjuvant chemicals included in vaccinations may enhance their antiviral effect
0
0
0
Many UK universities are in financial trouble but Queen Mary has the confidence to buy a large site in Whitechapel to expand its biomedical campus and then spend £750mn with partners developing it https://t.co/zzCdC9RdOk via @ft
ft.com
Queen Mary plans to develop £750mn biomedical campus after buying site from government
0
0
1
A new Welsh dragon raises $140mn to breathe fire into the moribund field of antidepressant development @cardiffuni
https://t.co/DVgjL3b3HB via @ft
ft.com
$140mn financing will allow Draig Therapeutics to move drug candidates into clinical trials
0
1
1
Best summer books of 2025: Environment, Science and Technology chosen by @pilitaclark @johnthornhillft and me
ft.com
Pilita Clark, Clive Cookson and John Thornhill select their best mid-year reads
1
0
3
A look into the science and business of weather forecasting with @Mikepeeljourno. Predictions have become much more accurate in past decades. AI promises further improvement -- so long as met data continues to flow freely https://t.co/ezeMCCj8JR via @ft
ft.com
Rapidly advancing technology is helping meteorologists to make more accurate and detailed forecasts even further into the future
0
0
1
Now available: Dark Mode in Hebbia. Built for long hours and deep focus – in a design that adapts to how investors and bankers actually work.
7
13
47
Another advance for organoid research. Creating the brain's pain pathway in a lab dish @Sergiu_P_Pasca
https://t.co/l5HlyxMPHM via @ft
ft.com
Research breakthrough promises new treatments for severe pain
0
0
3
“Scientists deploy AI to better predict wildfires helping to mitigate disasters such as the one that recently devastated Los Angeles” @clivecookson #AI #ClimateCrisis #Mitigation #Wildfires
ft.com
Model takes into account weather forecasts as well as factors such as levels of flammable vegetation and human activity
0
1
1
“Predictions for up to 15 days ahead expected to improve tracking of extreme events” @clivecookson #AI #Climate #Europe #ExtremeWeather #WeatherForecasting
ft.com
Predictions for up to 15 days ahead expected to improve tracking of extreme events
1
1
3
Exosome research is fast gathering pace https://t.co/JAshqzDCBS via @ft
ft.com
Research highlights how lifestyle and living conditions can substantially increase risk of early death and disease
1
1
3
After a short period of stunned silence, US scientists are beginning to fight back against Trump's myriad anti-science actions. My roundup at the end of an eventful AAAS meeting in Boston. @aaas
https://t.co/8m51GkbNuu via @ft
ft.com
AAAS chief says more disruption threatens to undermine crucial healthcare and research, ahead of next month’s fiscal bill
0
2
4